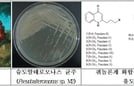

-
 ФЩРЬПЄХзХЉГюЗЮСі, МЧиЙйДй ЧиЛѓЧГЗТ ЙпРќДмСі АГЙпПЁ ЕЕПђ 'МіЗњОчПы ЧГЗТЙпРќ МГКёПюЙнМБ' БтМњЗЮ ЧбБЙЧиОчМіЛъЛъОїДыЛѓ ЧиОчМіЛъКЮРхАќЛѓ МіЛѓММАшРћРИЗЮ ФЃШЏАцПЁГЪСі, БзИАПЁГЪСіПЁ ДыЧб АќНЩАњ СЄУЅРЬ ГбУФГЊАэ РжДТ РЬ ЖЇ, БзЧиЛѓЧГЗТЙпРќРЬ СжИёЙоАэ РжДй. СЖМБ АБЙРЮ ЧбБЙРК ЖйОюГ МБЙк МГАш, АЧСЖБтМњАњ ХЭКѓ АГЙп БтМњРЛ АЎАэ ...2022.04.14 15:37
ФЩРЬПЄХзХЉГюЗЮСі, МЧиЙйДй ЧиЛѓЧГЗТ ЙпРќДмСі АГЙпПЁ ЕЕПђ 'МіЗњОчПы ЧГЗТЙпРќ МГКёПюЙнМБ' БтМњЗЮ ЧбБЙЧиОчМіЛъЛъОїДыЛѓ ЧиОчМіЛъКЮРхАќЛѓ МіЛѓММАшРћРИЗЮ ФЃШЏАцПЁГЪСі, БзИАПЁГЪСіПЁ ДыЧб АќНЩАњ СЄУЅРЬ ГбУФГЊАэ РжДТ РЬ ЖЇ, БзЧиЛѓЧГЗТЙпРќРЬ СжИёЙоАэ РжДй. СЖМБ АБЙРЮ ЧбБЙРК ЖйОюГ МБЙк МГАш, АЧСЖБтМњАњ ХЭКѓ АГЙп БтМњРЛ АЎАэ ...2022.04.14 15:37 -
 "ЛѕПьЧЅ ПЯЕЕБш" Бш МіУт, ГЏАГ ДоОвДй ПЯЕЕЙАЛъПЕОюСЖЧеЙ§РЮ, ЧбБЙЧиОчМіЛъЛъОїДыЛѓ ЧиОчМіЛъКЮРхАќЛѓ МіЛѓБЙЛъ БшРЧ МіУт СѕАЁММАЁ АЁЦФИЃДй. 2021Гт Бш МіУтРЬ БзЕПОШ КЮЕПРЧ 1РЇИІ СіФбПдДј ТќФЁ МіУтРЛ ГбОюМЙДй. БЙЛъ МіЛъЙА Сп ТќФЁ, Ад ЕюРЧ ПјЙА СпНЩ МіЛъЙА МіУтРК АЈМвЧб ЙнИщ, Бш, ОюЙЌ ЕюРЧ АЁАјНФЧА МіУт...2022.04.14 15:37
"ЛѕПьЧЅ ПЯЕЕБш" Бш МіУт, ГЏАГ ДоОвДй ПЯЕЕЙАЛъПЕОюСЖЧеЙ§РЮ, ЧбБЙЧиОчМіЛъЛъОїДыЛѓ ЧиОчМіЛъКЮРхАќЛѓ МіЛѓБЙЛъ БшРЧ МіУт СѕАЁММАЁ АЁЦФИЃДй. 2021Гт Бш МіУтРЬ БзЕПОШ КЮЕПРЧ 1РЇИІ СіФбПдДј ТќФЁ МіУтРЛ ГбОюМЙДй. БЙЛъ МіЛъЙА Сп ТќФЁ, Ад ЕюРЧ ПјЙА СпНЩ МіЛъЙА МіУтРК АЈМвЧб ЙнИщ, Бш, ОюЙЌ ЕюРЧ АЁАјНФЧА МіУт...2022.04.14 15:37 -
КгРКИлАд РЏЗЁ ЙЬЛ§ЙА, ЧЧКЮАГМБПЁ ЕЕПђЁІ ШРхЧА МіУт АсСЄ МіАњПј, КгРКИлАд РЏЗЁ ЙЬЛ§ЙАМ УЃРК ЙАСњЗЮ ШРхЧА Л§Лъ ЧиОчМіЛъКЮ БЙИГМіЛъАњЧаПј(ПјРх ПьЕПНФ, РЬЧЯ МіАњПј)РК ЙйРЬПРБтОїАњРЧ ЧљОїПЌБИЗЮ МіЛъЙЬЛ§ЙАЗЮКЮХЭ ЖйОюГ ЧЧКЮАГМБ ШПДЩ ЙАСњРЛ ЙпБМ, БтДЩМК ШРхЧАРЛ Л§ЛъЧи ЧиПмЗЮ МіУтЧбДйАэ 7РЯ ЙрЧћДй. МіАњПјРК "17ГтКЮХЭ Аќ...2022.04.07 11:34
КгРКИлАд РЏЗЁ ЙЬЛ§ЙА, ЧЧКЮАГМБПЁ ЕЕПђЁІ ШРхЧА МіУт АсСЄ МіАњПј, КгРКИлАд РЏЗЁ ЙЬЛ§ЙАМ УЃРК ЙАСњЗЮ ШРхЧА Л§Лъ ЧиОчМіЛъКЮ БЙИГМіЛъАњЧаПј(ПјРх ПьЕПНФ, РЬЧЯ МіАњПј)РК ЙйРЬПРБтОїАњРЧ ЧљОїПЌБИЗЮ МіЛъЙЬЛ§ЙАЗЮКЮХЭ ЖйОюГ ЧЧКЮАГМБ ШПДЩ ЙАСњРЛ ЙпБМ, БтДЩМК ШРхЧАРЛ Л§ЛъЧи ЧиПмЗЮ МіУтЧбДйАэ 7РЯ ЙрЧћДй. МіАњПјРК "17ГтКЮХЭ Аќ...2022.04.07 11:34 -
 МЧиЧиАцУЛ, 2022ГтЕЕ БЙЙЮБтРкДм И№С§ МЧиСіЙцЧиАцТћУЛ(УЛРх БшСОПэ)РК "2022ГтЕЕ МЧиСіЙцЧиАцТћУЛ БЙЙЮБтРкДм"РЛ И№С§ЧбДйАэ 3РЯ ЙрЧћДй.БЙЙЮБтРкДмРК МЧиЧиАцУЛРЧ ДйОчЧб МвНФРЛ УыРчИІ ХыЧи БтЛчПЭ ЛчСј, ФЋЕхДКНК, ПЕЛѓ ЕюРИЗЮ СІРлЧи БЙЙЮПЁАд ОЫИЎДТ ШАЕПРЛ ДуДчЧбДй.РЬЙј БЙЙЮБтРкДм МБЙпРЮПјРК Уб 10ИэРЬДй....2022.03.03 16:06
МЧиЧиАцУЛ, 2022ГтЕЕ БЙЙЮБтРкДм И№С§ МЧиСіЙцЧиАцТћУЛ(УЛРх БшСОПэ)РК "2022ГтЕЕ МЧиСіЙцЧиАцТћУЛ БЙЙЮБтРкДм"РЛ И№С§ЧбДйАэ 3РЯ ЙрЧћДй.БЙЙЮБтРкДмРК МЧиЧиАцУЛРЧ ДйОчЧб МвНФРЛ УыРчИІ ХыЧи БтЛчПЭ ЛчСј, ФЋЕхДКНК, ПЕЛѓ ЕюРИЗЮ СІРлЧи БЙЙЮПЁАд ОЫИЎДТ ШАЕПРЛ ДуДчЧбДй.РЬЙј БЙЙЮБтРкДм МБЙпРЮПјРК Уб 10ИэРЬДй....2022.03.03 16:06
-

- СІ13ШИ ЙйДйЛѓЛѓЧЯБт БзИВАјИ№Рќ, ДыЛѓПЁ МлРЬЕчЁЄБшМРКЁЄРЏПЙИА ОюИАРЬ
- [ОЫИВ] 13ШИ ОюИАРЬ ЙйДйЛѓЛѓЧЯБт БзИВАјИ№Рќ, 6Пљ 20РЯ СЂМі ИЖАЈ
- [ОЫИВ] "ЛѓЛѓРИЗЮ ИИГЊДТ ЙЬЗЁ ЙйДй" 2025Гт 'ЙйДй ЛѓЛѓЧЯБт' БзИВ АјИ№Рќ СЂМі
- "ОюИАРЬ ШАЁЕщРЧ ЙйДй УрСІ" ЧЯЗч МіУЕИэРЬ УЃДТ ЙйДйБзИВ АјИ№Рќ РќНУ
- "ПТАЁСЗРЬ ЧдВВ ГЊДЉДТ МіЛѓРЧ БтЛн"ЁІЙйДйЛѓЛѓЧЯБт БзИВАјИ№Рќ МКЗс
-

- "ОюИАРЬ ШАЁЕщРЧ ЙйДй УрСІ" ЧЯЗч МіУЕИэРЬ УЃДТ ЙйДйБзИВ АјИ№Рќ РќНУ
- "ПТАЁСЗРЬ ЧдВВ ГЊДЉДТ МіЛѓРЧ БтЛн"ЁІЙйДйЛѓЛѓЧЯБт БзИВАјИ№Рќ МКЗс
- ОчОчЙЎШРчДм, СІ7ШИ ЧбБЙЧиОчМіЛъЛъОїДыЛѓ ЧбБЙОюУЬОюЧзАјДмРЬЛчРхЛѓ МіЛѓ
- ЙшСиПЕ БЙШИРЧПј, СІ7ШИ ЧбБЙЧиОчМіЛъЛъОїДыЛѓ ИгДЯХѕЕЅРЬДыЧЅРЬЛчЛѓ МіЛѓ
- ЧбБЙЧиЛчБтМњ, СІ7ШИ ЧбБЙЧиОчМіЛъЛъОїДыЛѓ ЧиОчШЏАцАјДмРЬЛчРхЛѓ МіЛѓ

-

- СІ13ШИ ЙйДйЛѓЛѓЧЯБт БзИВАјИ№Рќ, ДыЛѓПЁ МлРЬЕчЁЄБшМРКЁЄРЏПЙИА ОюИАРЬ
- [ОЫИВ] 13ШИ ОюИАРЬ ЙйДйЛѓЛѓЧЯБт БзИВАјИ№Рќ, 6Пљ 20РЯ СЂМі ИЖАЈ
- [ОЫИВ] "ЛѓЛѓРИЗЮ ИИГЊДТ ЙЬЗЁ ЙйДй" 2025Гт 'ЙйДй ЛѓЛѓЧЯБт' БзИВ АјИ№Рќ СЂМі
- [ОЫИВ] СІ12ШИ ЙйДйЛѓЛѓЧЯБт БзИВАјИ№РќЁІДыЛѓПЁ МКРКПьЁЄГВЛѓЙЮЁЄЙкЙЮМ ОюИАРЬ
- [ОЫИВ] "БтЙпЧЯАэ ЕЖЦЏЧи" 12ШИ ЙйДйЛѓЛѓЧЯБт БзИВАјИ№Рќ НЩЛч ПЯЗс













